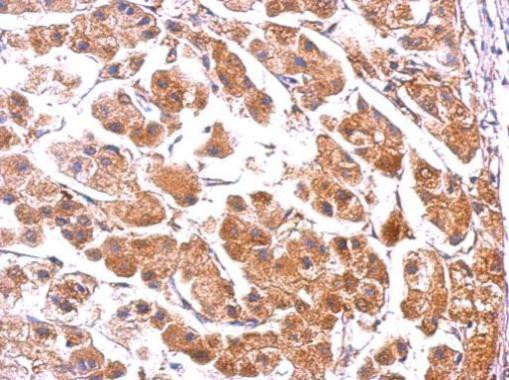
PUMA alpha Antibody in Immunohistochemistry (Paraffin) (IHC (P))

Search
Invitrogen
PUMA alpha Polyclonal Antibody
{{$productOrderCtrl.translations['antibody.pdp.commerceCard.promotion.promotions']}}
{{$productOrderCtrl.translations['antibody.pdp.commerceCard.promotion.viewpromo']}}
{{$productOrderCtrl.translations['antibody.pdp.commerceCard.promotion.promocode']}}: {{promo.promoCode}} {{promo.promoTitle}} {{promo.promoDescription}}. {{$productOrderCtrl.translations['antibody.pdp.commerceCard.promotion.learnmore']}}
产品信息
PA5-34755
种属反应
宿主/亚型
分类
类型
抗原
偶联物
形式
浓度
规格
纯化类型
保存液
内含物
保存条件
运输条件
RRID
产品详细信息
Recommended positive controls: K562, THP-1, HCT116 control 0hr, HCT116 treated 30uM cisplatin 24hr.
IHC notes, Requires antigen retrieval using heat mediated 10mM Citrate buffer (pH6.0) or Tris-EDTA buffer (pH8.0)
Store product as a concentrated solution. Centrifuge briefly prior to opening the vial.
靶标信息
PUMA is one of the pro-apoptotic Bcl-2 family members including Bax and Noxa, which are also transcriptional targets of p53. The PUMA gene encodes two BH3 domain-containing proteins termed PUMA-a and PUMA-b. PUMA proteins bind Bcl-2, localize to the mitochondria, and induce cytochrome c release and apoptosis in response to p53. PUMA may be a direct mediator of p53-induced apoptosis. Antisense inhibition of PUMA expression reduced the apoptotic response to p53, and PUMA is likely to play a role in mediating p53-induced cell death through the cytochrome c/Apaf-1-dependent pathway.
⚠WARNING: This product can expose you to chemicals including mercury, which is known to the State of California to cause birth defects or other reproductive harm. For more information go to www.P65Warnings.ca.gov.
仅用于科研。不用于诊断过程。未经明确授权不得转售。
篇参考文献 (0)
生物信息学
蛋白别名: Bcl-2-binding component 3, isoforms 1/2; Bcl-2-binding component 3, isoforms 3/4; FLJ42994; JFY-1; p53 up-regulated modulator of apoptosis; p53-induced BH3-only protein; p53-upregulated modulator of apoptosis; unnamed protein product
基因别名: BBC3; JFY-1; JFY1; PUMA
UniProt ID: (Human) Q96PG8
Entrez Gene ID: (Human) 27113